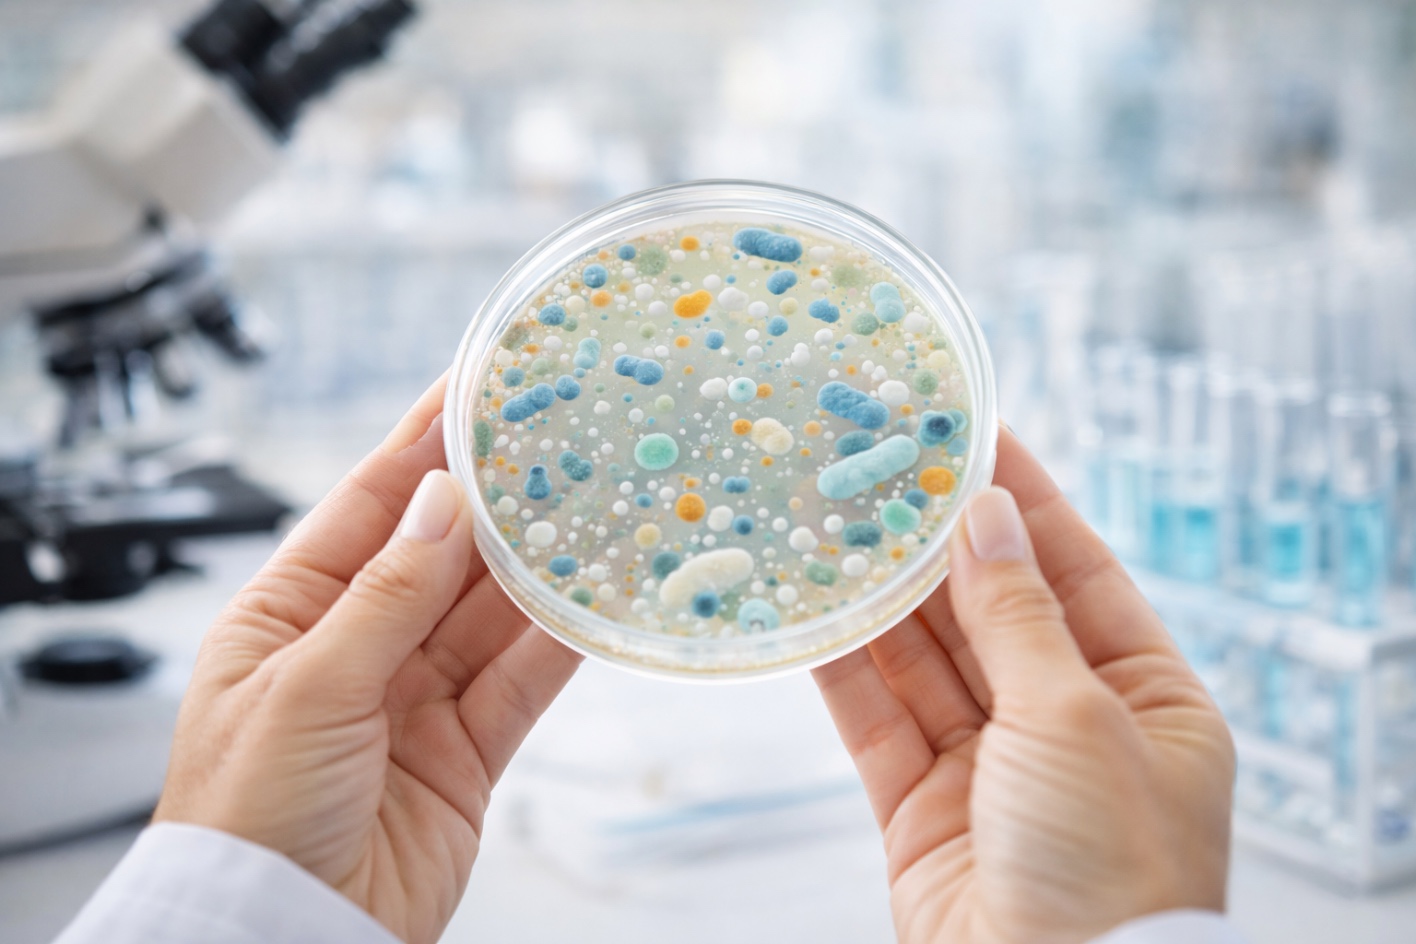
Placa de laboratorio con cultivo bacteriano representando el estudio de probióticos y microbiota intestinal

Los cálculos renales, conocidos comúnmente como piedras en el riñón, afectan aproximadamente al 15 % de la población en países desarrollados. Uno de los principales retos es su alta tasa de recurrencia, que puede alcanzar entre un 30 % y un 50 % en los cinco años posteriores si no se aplican medidas preventivas.
La litiasis renal es una condición multifactorial en la que intervienen factores metabólicos, dietéticos e intestinales. En los últimos años, la investigación sobre microbiota y probióticos específicos ha abierto una nueva vía en la prevención de los cálculos renales.
¿Por qué se forman las piedras en el riñón?
Los principales factores implicados en la formación de cálculos renales son:
- Exceso de calcio en orina (hipercalciuria)
- Déficit de citrato (hipocitraturia)
- Exceso de oxalato urinario (hiperoxaluria)
Aproximadamente el 80 % de los cálculos están formados por oxalato cálcico. Cuando existe un exceso de oxalato en la orina, este puede combinarse con el calcio y formar cristales que, con el tiempo, se convierten en cálculos.
Oxalatos y alimentación: ¿qué relación existe?
Algunos alimentos contienen cantidades elevadas de oxalatos, como por ejemplo:
- Espinacas
- Remolacha
- Frutos secos
- Chocolate
- Té
Para reducir el riesgo de formación de cálculos renales se recomienda:
- Mantener una buena hidratación diaria
- Moderar el consumo de alimentos ricos en oxalatos
- Asegurar un aporte adecuado de calcio en la dieta
Microbiota intestinal y metabolismo del oxalato
La investigación reciente ha puesto el foco en la microbiota intestinal y su posible relación con la salud renal. Algunas bacterias intestinales pueden intervenir en el metabolismo del oxalato antes de que este sea absorbido, lo que podría influir en sus niveles urinarios.
¿Qué papel pueden tener los probióticos?
Determinadas cepas probióticas, como Lactobacillus amylovorus, han sido estudiadas por su posible papel en la degradación intestinal del oxalato. En modelos experimentales, la combinación con Phyllanthus niruri mostró una reducción significativa de los niveles de oxalato urinario.
Un enfoque integral en el cuidado renal
La prevención de los cálculos renales puede incluir:
- Hidratación adecuada
- Pautas dietéticas personalizadas
- Seguimiento médico
- En algunos casos, complementos específicos
Herbensurina® Probiotic integra Lactobacillus amylovorus SGL 1, extracto de Phyllanthus niruri e Inulina, dentro de un enfoque que contempla la relación entre microbiota intestinal y metabolismo del oxalato.

Preguntas frecuentes sobre probióticos y cálculos renales
¿Cuál es el tipo de cálculo renal más frecuente?
El cálculo de oxalato cálcico es el más habitual, representando aproximadamente el 80 % de los casos.
¿Beber agua ayuda a prevenir las piedras en el riñón?
Sí. Una adecuada hidratación favorece la dilución de la orina y reduce el riesgo de cristalización.
¿Los probióticos sustituyen el tratamiento médico?
No. Pueden formar parte de una estrategia complementaria, pero no sustituyen el tratamiento indicado por el profesional sanitario.
¿Cuándo conviene consultar con un profesional sanitario?
Ante dolor intenso, fiebre, infecciones urinarias recurrentes o antecedentes repetidos de litiasis renal.
Cuidar la salud renal desde una perspectiva global
La salud renal es el resultado de múltiples factores. Comprender la relación entre dieta, hidratación y microbiota permite adoptar un enfoque más completo en la prevención de los cálculos renales.
Ante cualquier duda, consulta siempre con tu farmacéutico o profesional sanitario de confianza.




